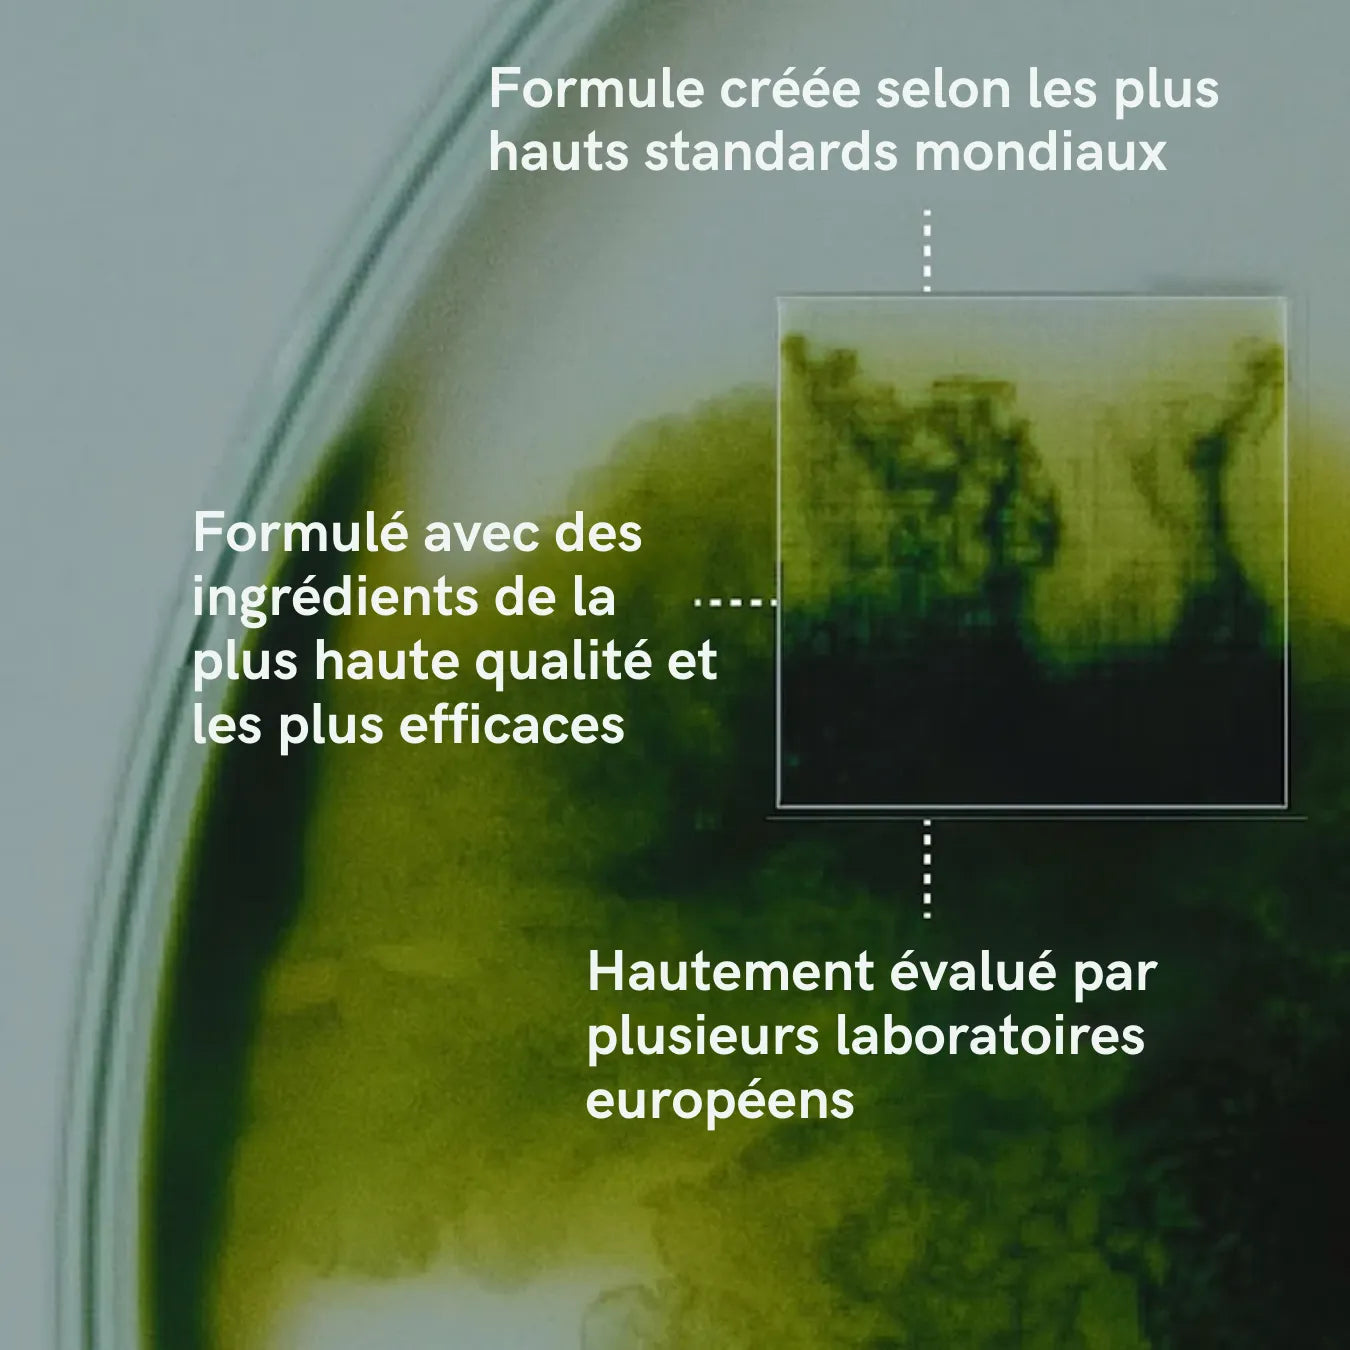

What it does:
- Helps reduce hair loss and support natural growth
- Helps reduce hair loss and support natural growth
- Helps reduce hair loss and support natural growth
Capilia Longa™
An effective natural compound that demonstrated up to 89% reduction in hair loss and up to 52% improvement in hair density in individual studies.
Capilia Longa™
An effective natural compound that demonstrated up to 89% reduction in hair loss and up to 52% improvement in hair density in individual studies.
Capilia Longa™
An effective natural compound that demonstrated up to 89% reduction in hair loss and up to 52% improvement in hair density in individual studies.
We put our formula through independent clinical testing to make sure it works in real life, not just on paper. The results:
- Visible results in as little as 45 days
- Visible results in as little as 45 days
- Visible results in as little as 45 days